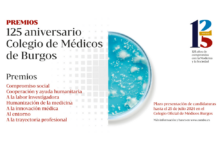

La segunda planta del Fórum Evolución se convertirá desde el 17 de octubre y hasta el 14 de noviembre en un escenario único en el que recrear cómo ha evolucionado la Medicina y sus profesionales desde 1899 hasta 2024.
El Colegio de Médicos de Burgos lleva todo el año trabajando en una muestra de gran formato que verá la luz la próxima semana y que permitirá repasar la historia de la Medicina en la provincia de Burgos, conocer la historia de sus protagonistas, entender cómo eran los hospitales de antes y de ahora, además de admirar el instrumental y la tecnología médica utilizada (todo material original) por facultativos de distintas épocas para mejorar la calidad de vida de cientos de ciudadanos en la ciudad y su provincia.
El Colegio de Médicos de Burgos conmemora su 125 aniversario con una exposición que narra la historia de la Medicina y de la profesión médica en su conjunto desde 1899. Una muestra inédita por su importante valor histórico y documental que permitirá durante el mes de octubre y de noviembre, que miles de burgaleses puedan conocer el papel, la importancia y la evolución de la Medicina y el de sus protagonistas en este tiempo.
El presidente del Colegio de Médicos de Burgos, Joaquín Fernández de Valderrama; el concejal y presidente de la Sociedad Promueve, César Barriada, además de los comisarios de la muestra los doctores José Manuel López Gómez y Martín de Frutos, han presentado hoy en la sala de prensa del Fórum Evolución, el contenido de una exposición “impactante” que recorre la historia de la ciudad y de su provincia en “un viaje fascinante” que ilusionará a facultativos y a pacientes.

Comisariada por los doctores José Manuel López Gómez y Martín de Frutos ofrece un viaje en el tiempo a quien la visite para conocer el momento de nacimiento del Colegio de Médicos de Burgos a finales del siglo XIX. Y lo hace, además, de la mano de sus protagonistas. Hombres y mujeres que en un siglo muy diferente al que ahora vivimos pusieron su conocimiento y su buen hacer profesional para mejorar la calidad de vida de cientos de burgaleses en toda la provincia.
Rescatar del olvido a los médicos del siglo XIX y XX
Gracias al impresionante fondo documental y a la encomiable labor del Dr. e historiador López Gómez- uno de los principales valedores de la exposición- se ha rescatado del olvido los nombres y los rostros de personajes como Rafael Vara, Felisa Martínez, Mariano Loustau, Ignacio López Sáiz y muchos otros, protagonistas todos de la Medicina del siglo XIX y el XX en la provincia de Burgos, y en otros puntos del país.

Y nada mejor para conocer su vida y su obra, que de la mano de documentos originales, manuscritos, instrumental propio de los facultativos que ha conservado y custodiado el médico e historiador, que aporta para esta muestra buena parte del importante de un fondo documental único que cuenta con manuscritos y cartas del propio Gregorio Marañón, instantáneas familiares, además de cartillas y libros de estudio.
Los paneles que repasan la vida de los 20 facultativos más señalados desde 1899 hasta mediados del siglo XX además de historia suman actualidad, ya que para poder desarrollarlos ha sido necesario utilizar Inteligencia Artificial con el objetivo de dotar de mayor realismo a sus protagonistas. “Contábamos con fotos dañadas, o tocadas por el paso del tiempo, y gracias al uso de la tecnología, hemos podido recuperar la mirada y el rostro de algunos de sus protagonistas”, aseveran los responsables.
Recreación con materiales originales
Un despacho médico original de las primeras décadas del siglo XX, junto a instrumental y tecnología médica del siglo pasado que incluyen vitrinas originales y material que copó las estancias de los antiguos Hospitales Provincial y Militar de Burgos, convierten en única a una muestra que pone en valor el compromiso de estos 125 años con la Medicina y con la sociedad. Las donaciones de facultativos particulares, familiares de médicos y del Complejo Asistencial Universitario de Burgos (CAUBU) lo han hecho posible.
El visitante también podrá conocer la historia de los hospitales y complejos asistenciales de la provincia, además de comprobar el gran avance que se ha producido en poco más de un siglo en el terreno médico y sanitario mediante una línea del tiempo que incluye hitos, momentos y que da cuenta del progreso conseguido desde 1899 hasta la fecha.

Asimismo, podrá ser testigo de las portadas y noticias que han narrado hitos como la gripe de 1918, la inauguración de las 300 camas, la aparición del VIH o la llegada de la pandemia Covid19, entre otras. Noticias de ayer y de hoy que han sido rescatadas de la hemeroteca para sumar rigor histórico a la exposición, junto a un conjunto de instantáneas que forman parte del imaginario colectivo. Todo ello gracias a la colaboración de fotógrafos locales y de medios de comunicación de la provincia, también presentes en la muestra.
Y como no podía ser de otra manera, el Colegio de Médicos de Burgos también repasa su historia. Y lo hace con un homenaje a las personas que han ocupado cargos en las distintas juntas directivas, con especial mirada a sus presidentes, sin olvidar las sedes por las que ha pasado desde finales del siglo XIX hasta la fecha.
El resultado, una muestra completa y única que podrá verse desde el 17 de octubre y hasta el 14 de noviembre y que buscará después recorrer otros puntos de la provincia.
Organizada por el Colegio Oficial de Médicos de Burgos, cuenta con el patrocinio del Ayuntamiento de Burgos, el apoyo de la Diputación de Burgos, y de la Junta de Castilla y León. Asimismo, han contribuido a su realización Recoletas Salud, AMA, la Cámara de Comercio e Industria de Burgos, así como otros colaboradores como el Archivo Municipal de Burgos y Diario de Burgos, entre otros.